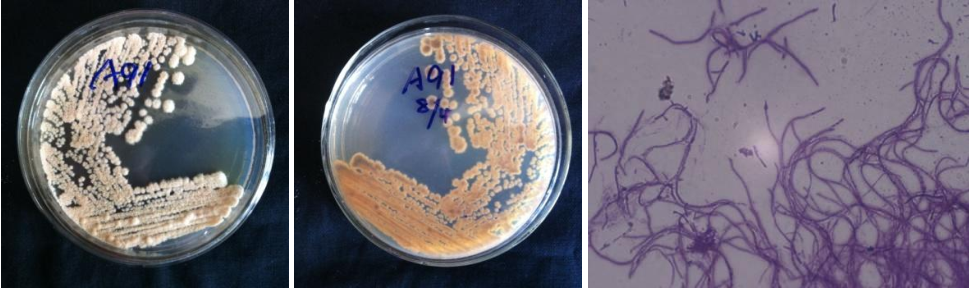

Loading...
| StrainNO | A91 |
| Classification | Amycolatopsis |
| 16s rDNA sequence | CGTGGGTAATCTGCCCTGTACTCTGGGATAAGCCTTGGAAACGGGGTCTAATACCGGATATCACCGACTCTCGCATGGGGGTTGG TTGAAAGTTTCGGCGGTRCAGGATGAGCCCGCGGCCTATCAGCTTGTTGGTGGGGTGATGGCCTACCAAGGCGACGACGGGTAGC CGGCCTGAGAGGGTGACCGGCCACACTGGGACTGAGACACGGCCCAGACTCCTACGGGAGGCAGCAGTGGGGAATATTGCACAAT GGGCGGAAGCCTGATGCAGCGACGCCGCGTGAGGGATGACGGCCTTCGGGTTGTAAACCTCTTTCGCCAGGGACGAAGCGCAAGT GACGGTACCTGGATAAGAAGCACCGGCTAACTACGTGCCAGCAGCCGCGGTAATACGTAGGGTGCGAGCGTTGTCCGGATTTATT GGGCGTAAAGAGCTCGTAGGCGGTTTGTCGCGTCGTTCGTGAAAACTCCACGCTTAACGTGGAGCGTGCGGGCGATACGGGCAGA CTTGAGTTCGGTAGGGGAGACTGGAATTCCTGGTGTAGCGGTGAAATGCGCAGATATCAGGAGGAACACCGGTGGCGAAGGCGGG TCTCTGGGCCGATACTGACGCTGAGGAGCGAAAGCGTGGGGAGCGAACAGGATTAGATACCCTGGTAGTCCACGCTGTAAACGTT GGGCGCTAGGTGTGGGTGACATTCCACGTTGTCCGTGCCGTAGCTAACGCATTAAGCGCCCCGCCTGGGGAGTACGGCCGCAAGG CTAAAACTCAAAGGAATTGACGGGGGCCCGCACAAGCGGCGGAGCATGTGGATTAATTCGATGCAACGCGAAGAACCTTACCTGG GCTTGACATGCACTGGAAACCAGTAGAGATATTGGCCCCCTTGTGGCCGGTGTACAGGTGGTGCATGGCTGTCGTCAGCTCGTGT CGTGAGATGTTGGGTTAAGTCCCGCAACGAGCGCAACCCTTATCCTACGTTGCCAGCAAGTAAAGTTGGGGACTCGTGGGAGACT GCCGGGGTCAACTCGGAGGAAGGTGGGGATGACGTCAAGTCATCATGCCCCTTATGTCCAGGGCTTCACACATGCTACAATGGCT GGTACAGAGGGCTGCGATACCGCGAGGTGGAGCGAATCCCTTAAAGCCGGTCTCAGTTCGGATCGCAGTCTGCAACTCGACTGCG TGAAGTCGGAGTCGCTAGTAATCGCAGATCAGCAACGCTGCGGTGAATACGTTCCCGGGCCTTGTACACACCGCCCGTCACGTCA TGAAAGTCGGTAACACCCGAAGCCCATGGCCCAACCCTTCGGGGAGGGAGTGGTCGAAGGTGG |
| Strain Morphology Photos | |
| Morphological Description | Mycelia branch;septum;fracture;short coarse spore pile bald type;back ivory yellow;few white spore pile |